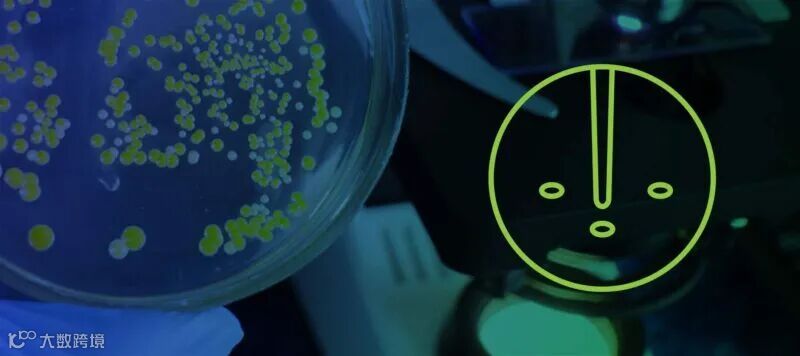

菌落挑选的过程包括选择一个单一菌株的菌落,即纯微生物,以便以后可以复制。菌落挑选用于大量应用,包括聚合酶链式反应(PCR)、质谱法、蛋白质纯化等。几十年前,所有的菌落挑选都是手工完成的,这对实验室技术人员来说可能既耗时又困难。然而,随着实验室自动化的进步,自动化菌落挑选最大限度地减少了人工劳动,效率更高,大多数机器每小时可以处理数千个样本。此外,菌落挑选机器人比人工更准确。了解如何通过自动化菌落挑选仪提高实验室的准确性和效率,以及这将如何对您的整个工作流程产生积极影响,请继续阅读。
实验室自动化和自动菌落挑选
有几种在实验室中使用自动菌落挑选仪的方式。如果你的目标是打造一个高通量的实验室,那么自动化、高通量的菌落挑选仪是最佳选择。使用微生物菌落挑选仪,人为失误的风险最小。它消除了手动过程中不必要的样品交换。如果样本被交换,那么这将阻碍未来对菌落的任何探索。一台自动化菌落挑选仪几乎不需要人工,每小时可以处理2500个菌落。不是专门为高通量设计的小型菌落挑选仪仍然可以每小时处理数百个菌落,但需要更多的人机交互。
使用自动化改进您的工作流
实验室中的全自动化工作流程具有成本效益、高效性,并可提高准确性,有助于克服菌落挑选方面的挑战。小规模应用可以手动进行,但大规模应用无法在不牺牲时间和精度的情况下手动执行。机械臂集成是在使用标准微孔板格式下实现多个实验室仪器自动化的最常见方式。机械臂集成可用于自动移液、PCR仪和快速菌落分离。
在实验室中使用自动化工具,如自动菌落挑选仪,也有助于减少交叉污染,提供最精确的菌落选择,并在您的工作流程中提供数据管理。许多自动菌落挑选系统还配有高分辨率摄像头和条形码读取器,有助于数据的可追溯性和清晰的数据库。
菌落挑选的创新工具
自动化菌落挑选并不是什么新鲜事;它已经存在一段时间了。尽管一些实验应用仍然使用手动挑选,但重点仍然在实验室自动化和自动挑选上。Hudson Robotics开发了两种创新工具,也可以提高您的准确性和重复性。LabLinx微孔板输送系统与PlateCrane EX无缝配合并且可以将普通的液体处理器变成完全自动化的工作单元。LabLinx stacker允许仪器与几个不同的协议集成:
移动所有实验室用具:微孔板、深孔板、吸头架、离心管架
将任何与之兼容的实验室仪器连接在一起
在现有的工作台空间上构建高速自动化工作单元
轻松重新配置以适应新设备和分析
易于安装在标准实验室罩内
LabLinx系统可以同时操作多个微孔板,远远超过单个机械臂集成所能提供的功能。这些新的配置和开发对高通量实验室非常有益,并且可以用于多种不同的应用。这种实验室自动化改善了菌落的自动挑选,全面实现了更高的准确性、效率和重复性。
参考来源
https://www.moleculardevices.com/lab-notes/clone-screening/synthetic-biology-automation
https://www.lab-services.nl/en/application-notes/automatizing-colony-picking-workflows
https://www.ncbi.nlm.nih.gov/pmc/articles/PMC4746068/
推荐阅读:
>>Hudson Robotics获Pharma Tech Outlook 2023年十大实验室自动化解决方案提供商殊荣
>>如何将PlateCrane集成到您的实验室
>>如何提高流式细胞仪的处理通量?
>>自动化您的合成生物学工作流程
>>您的菌落挑选工具指南
>>关于微生物菌落挑选仪的5个考虑点
>>RapidPick:高低通量皆可的自动克隆菌落挑选仪
>>合成生物学简史
>>为什么推荐使用自动移液器?
>>思维转个弯,神经退行性疾病诊断通量翻翻翻
>>实验室pH测量仪使用指南
>>来看看Novartis如何使用PlateCrane/Octet组合来加速抗体筛选和消除人工瓶颈
>>如何选购自动化菌落挑选设备
>>让我们带你将合成生物学自动化概念变成现实
>>自动菌落计数器的好处
>>需要精确的微孔板跟踪吗?
>>自动化步骤或整个过程,打破合成生物学僵局
>>Hudson帮你打开格局,你的实验室可以更加系统自动化
>>合成生物学整体流程如何自动化
>>让实验室多个流程变成统一的高通量、多任务分析系统
>>Rapid_pH通过温度补偿提供更多自动化和灵活性
>>Rapid_pH:带温度补偿的全自动pH检测系统
>>pH计保养攻略!
>>LabLinx轨道输送系统,联通实验的每一个环节
>>pH计校准解决方案
>>RapidPick Complete全自动克隆菌落挑选工作站
>>为实验室选择合适的电子pH计
>>伯齐推出Hudson全自动ELISA检测工作站
>>如何轻松制备并保护RNA样本?
>>案例:如何提高ELISA处理能力
>>为什么菌落在微生物学研究中很重要
>>从复杂到简单,我们可以帮助您简化实验室流程
>>微生物实验室适用哪种pH计呢?
>>如何精准追踪微孔板处理
>>如何正确使用pH计
>>DNA/RNA样本纯化如何确保所有样品孔都高效且同效率洗脱
>>菌落形态定义:它是什么以及如何识别
>>描述菌落形态的基本指南
>>突破通量限制,实现蛋白定量全自动化,加速抗体筛选
>>自动pH计的五大特点
>>20针菌落挑选仪! 一心四用: 挑样,接种,清洗,消毒 无间断进行!
>>稳定的检测和分析需要稳定的pH检测
>>“变形金刚”式工作单元拯救被挤压的实验空间
>>如何让流式细胞仪、RT-PCR系统或多功能酶标仪微孔板装载更简单?
>>如何让微孔板处理自动化
>>如何最大限度地提高自动化实验室设备的投资回报
>>条形码标签在自动化过程中的使用
>>如何让ELISA自动化加速COVID-19检测
>>MINI TALKS:5分钟全面了解如何选择合适的自动菌落挑选仪
>>DNA/RNA样本纯化如何确保所有样品孔都高效且同效率洗脱
>>如何为实验室搭建自动微孔板处理系统
>>如何正确选择自动克隆菌落挑选仪
>>如何为你的实验室实现自动化
>>肠道微生物研究最佳组合
>>RapidPick:高低通量皆可的自动克隆菌落挑选仪
>>Hudson RapidPick:帮你解决菌落挑选问题
>>您需要了解的ELISA自动化的优点和基础
>>如何充分利用你的微孔板处理系统
>>你的实验室适合什么样的菌落挑选仪?
>>Hudson Rapid_pH:助力pH检测的应用及其自动化
>>Hudson Micro10x:非接触式分液器是加快冠状病毒检测的理想工具!
>>挑菌:人工还是自动化?
>>Hudson Robotics:增加流式细胞仪COVID-19检测通量
>>Hudson:早期诊断帕金森高通量快速检测手段
>>还用牙签挑菌落吗?
>>Hudson Robotics:自动化COVID-19研究的核酸/蛋白提取纯化
>>Hudson Robotics:增加流式细胞仪COVID-19检测通量
>>挑菌原来可以这样简单方便!
>>Rapid_pH 自动pH检测仪——带温度补偿的pH计
>>小身材高通量菌落挑选仪,自动化so easy!
>>Hudson生物合成自动化方案
>>Hudson为您定制实验室自动化方案
>>pH值检测自动化,更高的通量和效率
>>新品推荐:Hudson PlateCrane SciClops机械臂
>>高通量自动化pH定量新方案
>>新品推荐:Rapid_pH™ pH值自动测定仪
>>重磅推荐:Hudson RapidPick自动克隆菌落挑选仪
欢迎关注进科驰安官方微信(微信公众号:Bio-Gene)
回复:Hudson,查看更多相关视频
长按/扫描以下二维码可识别关注公众号

广州进科驰安科技有限公司
Bio-Gene Technology Ltd.
热线:176 2009 3784
www.bio-gene.com.cn
marketing@bio-gene.com.cn
香港 北京 上海 广州 济南

